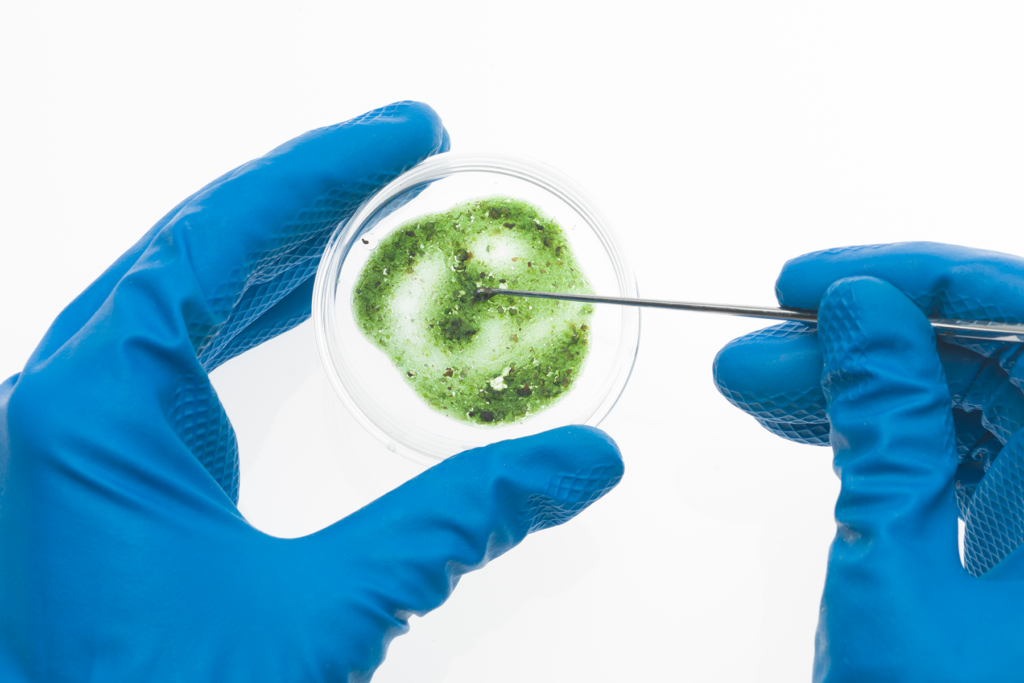
Cannabis Microbiological Testing

Comprehensive Cannabis Microbial Screening for Safety, Compliance & Product Integrity
At ChemHistory, our Microbiological Testing services help cannabis cultivators, manufacturers, and brands ensure products are free from harmful microbial contamination and meet regulatory safety requirements. Using validated laboratory methods and advanced analytical techniques, we detect and quantify microbial organisms that may compromise product safety, stability, or shelf life. Accurate microbial testing protects consumer health, supports regulatory approval, and helps maintain consistent, high-quality cannabis products.
What is Cannabis Microbiological Testing?
Microbiological testing identifies the presence of bacteria, yeast, mold, and pathogenic organisms that can develop during cultivation, harvesting, drying, processing, or storage.
Cannabis products may be vulnerable to microbial contamination due to:
- Moisture levels during drying or curing
- Environmental exposure during cultivation
- Handling and processing conditions
- Storage and packaging environments
Testing confirms microbial levels remain within allowable limits established by state cannabis regulations and safety guidelines.
microorganisims We Screen For
ChemHistory tests for key regulated microbial contaminants, including:
Pathogenic Bacteria
Indicator & Total Counts
Specified Mold Species
- Salmonella species
- Escherichia coli (E. coli)
- Total aerobic microbial count (TAMC)
- Total yeast and mold count (TYMC)
- Aspergillus fumigatus
- Aspergillus flavus
- Aspergillus niger
- Aspergillus terreus
Products We Test
Our potency testing services apply to:

Cannabis Flower

Concentrates & Extracts

Vape Cartriges & Oils

Edibles & Infused Beverages

Tinctures

Topicals

Destilates & Isolates

Hemp Derived Products
Our Testing Methodology
ChemHistory uses validated culture-based methods and/or rapid molecular detection technologies (such as qPCR) to identify microbial contamination with high sensitivity and accuracy.

Our process includes:
Controlled sample handling and preparation
Selective microbial enrichment and detection protocols
Quantitative microbial enumeration
Pathogen-specific screening where required
Strict quality control and validated procedures
Compliance-ready reporting aligned with regulatory thresholds
This approach ensures reliable detection, reproducibility, and defensible results for cannabis product safety evaluations.
Why Microbiological Testing Matters
Protect Consumer Health
Harmful microbes can cause serious illness, especially for immunocompromised consumers. Testing ensures products are safe for inhalation or consumption.
Meet Mandatory Cannabis Regulations
Most regulated cannabis markets require microbial testing prior to product sale or distribution.
Preserve Product Quality & Shelf Life
Microbial contamination can degrade cannabinoids, terpenes, and product stability.
Reduce Risk of Recalls or Batch Failures
Routine testing helps identify contamination early and prevent costly compliance issues.
Why Choose ChemHistory?
- Specialized cannabis analytical testing laboratory
- High-precision cannabinoid quantification methods
- Fast turnaround options for production timelines
- Clear reporting and Certificates of Analysis (COA)
- Expert support for cultivators, manufacturers, and brands
Turnaround & Reporting
- Efficient sample submission and tracking
- Priority testing available for urgent batches
- Easy-to-read cannabinoid breakdown reports
- COA documentation accepted by regulators, retailers, and distributors
- Technical support interpreting results or investigating discrepancies
rEQUEST MICROBIOLGICAL TESTING
Ensure your cannabis products meet safety standards and regulatory requirements.
Contact ChemHistory today to request a quote, schedule testing, or speak with our laboratory team about your microbial compliance needs.
